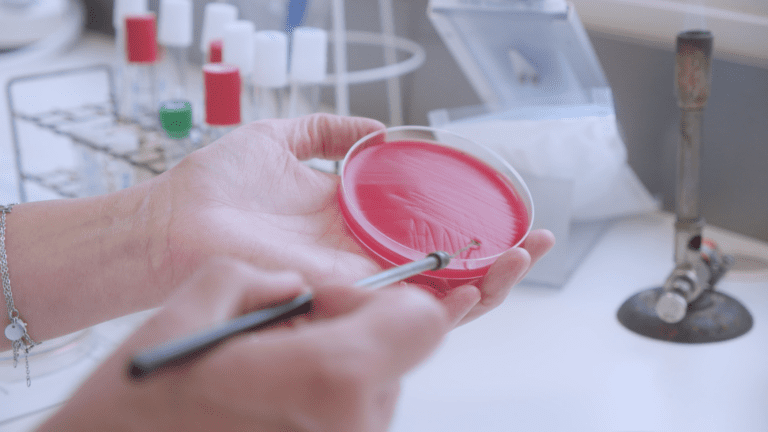
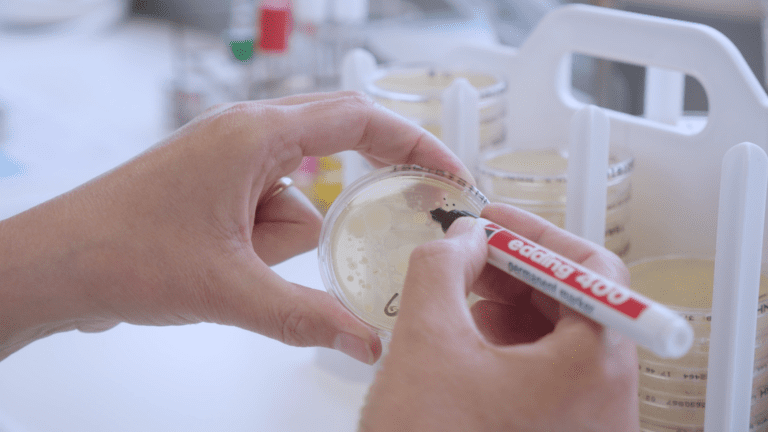

Bij DAC ZuidOost beschikken we over een in-huis laboratorium waar dagelijks met zorg en precisie gewerkt wordt aan diagnostiek voor een breed scala aan diersoorten. Ons deskundige team van analisten combineert jarenlange ervaring met actuele kennis om snel en betrouwbaar resultaat te leveren.
Kwaliteit staat bij ons centraal. Door middel van interne controles en deelname aan externe kwaliteitsrondzendingen garanderen we constante nauwkeurigheid en betrouwbaarheid van onze analyses.
Inzendformulieren
Hier vindt u gemakkelijk inzendformulieren voor het afgeven van monsters:
Team Laboratorium
Ons team bestaat uit gemotiveerde professionals met uiteenlopende achtergronden die hun passie voor diergezondheid inzetten voor het beste diagnostisch resultaat. Door regelmatige bijscholing en het volgen van de nieuwste ontwikkelingen in het vakgebied, blijven wij altijd up-to-date — en dat merkt u in de kwaliteit van onze dienstverlening.
Visie
Bij ons staat uw diergezondheid centraal en streven we naar snelle, betrouwbare en hoogwaardige veterinaire diagnostiek, zodat u snel duidelijkheid hebt en de beste zorg kunt bieden. Met een modern laboratorium dat voortdurend meegroeit met de nieuwste ontwikkelingen op veterinair gebied, zorgen we dat u kunt vertrouwen op actuele kennis, persoonlijke service en professionele ondersteuning.
Aanbod
Ons laboratorium: breed aanbod, betrouwbare resultaten
Ons veterinaire laboratorium biedt een uitgebreid pakket aan diagnostisch onderzoek voor verschillende diersoorten. We combineren kwaliteit met snelheid en nauwkeurigheid, zodat u verzekerd bent van betrouwbare uitslagen die bijdragen aan de beste zorg voor uw dieren.
Wij bieden onder andere:
- Bacteriologisch onderzoek – geschikt voor diverse materialen van meerdere diersoorten
- Celgetalbepaling – gericht op melkmonsters
- Antibioticagevoeligheidstest – geschikt voor verschillende diersoorten
- Parasitologisch onderzoek – geschikt voor mestonderzoek bij meerdere diersoorten
- Urineonderzoek – voor diverse diersoorten
- Serologie via ELISA – met name gericht op varkens
- Klinisch bloedbeeld – breed toepasbaar op meerdere diersoorten
- Hematologisch onderzoek – voor inzicht in de bloedwaardes van diverse diersoorten
- Microscopisch onderzoek op ectoparasieten – voor snelle detectie van huidparasieten
Daarnaast zijn wij HOSOWO-gecertificeerd voor de monstername en het uitvoeren van hygiënogrammen in pluimveestallen. Hiermee voldoen wij aan alle wettelijke eisen en kwaliteitsnormen binnen de sector.